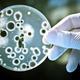
Como se reproducen las bacterias 3

-
Genentech, Inc., informa la producción en bacterias, por primera vez, de una proteína humana: somatostatina (factor inhibitorio de la liberación de hormona de crecimiento). Walter Gilbert y Allan Maxam desarrollan un método para secuenciar el ADN por degradación química, mientras que Sanger y sus colegas proponen un método de secuenciación enzimático que rápidamente se transformaría en el método de elección de los investigadores.
-
Genentech, Inc. y un centro médico anuncian la producción exitosa a escala de laboratorio de insulina humana, utilizando la tecnología del ADN recombinante. Ese año, David Botstein y colaboradores, descubren que la aplicación de enzimas de restricción al ADN de diferentes individuos genera una serie única e individual de fragmentos, pudiendo ser este patrón usado como una “huella digital” genética. A este tipo de “marcador molecular” se lo conoce como RFLP
-
La Suprema Corte de EE.UU. establece que, en su país, los organismos modificados genéticamente son patentables y, en 1980, permite a la compañía petrolera Exxon patentar un microorganismo degradador de petróleo.
-
Bill Rutter y Pablo Valenzuela publican un sistema de producción del antígeno de superficie del virus causal de la hepatitis B, en levaduras, dando los primeros pasos en el desarrollo de la vacuna recombinante. Científicos producen los primeros animales transgénicos: son ratones. En el área vegetal, se obtienen los primeros callos vegetales transformados genéticamente.
-
Genentech, Inc. recibe la aprobación de la Administración de Alimentos y Drogas de EE.UU. (en inglés, FDA) para comercializar la insulina humana recombinante (producida en E. coli), aprobando así la primera droga generada por esta técnica.
-
Laboratorios de EE.UU. y Francia aíslan el virus del HIV. Un estudio de una familia en Venezuela con la enfermedad de Huntington, muestra un patrón distinto y característico de RFLP en los individuos enfermos, llevando al desarrollo de un test de diagnóstico basado en dicha metodología. El mismo método revelará patrones característicos de las enfermedades fibrosis quística y distrofia muscular, entre otras. K. Mullis y colegas desarrollan una técnica para multiplicar fuera de la célula fragmento
-
Chiron Corp. anuncia el clonado y la secuenciación del virus de la inmunodeficiencia humana (VIH), descubierto en 1983; Alec Jeffrey desarrolla la técnica de “huella genética” para identificar individuos.
-
Se realizan ensayos de campo por primera vez, de plantas transgénicas resistentes a insectos, virus y bacterias, en EE.UU. y Europa. En EE.UU. la Agencia de Protección Ambiental (EPA, en inglés) aprueba la liberación del primer cultivo modificado por ingeniería genética: tabaco. El NIH, por su parte, aprueba guías para realizar ensayos clínicos de terapia génica en humanos. Las empresas Caltech y Applied Biosystems, Inc, desarrollan el secuenciador automático de ADN por fluorescencia. La FDA oto
-
Se generan plantas transgénicas para resistencia a insectos (mediante proteína de Bacillus thuringiensis) y resistencia a herbicidas. También se obtienen plantas de algodón transgénicas, y se desarrolla la técnica de bombardeo génico. Se aprueba la vacuna recombinante para la hepatitis B: Recombivax-HB®
-
Se otorga la primera patente a investigadores de Harvard sobre un animal genéticamente modificado: es un ratón altamente susceptible al cáncer de mama. En el área vegetal, se transforman genéticamente plantas de soja y arroz, y comienzan los ensayos a campo con las plantas de tomate transgénicas de maduración retardada desarrolladas por Calgene.
-
Se crea el Centro Nacional para la investigación del Genoma Humano en EE.UU., dirigido por James Watson, con el objetivo de mapear y secuenciar el genoma humano completo para el año 2005, y contará para ello con la suma de 3 mil millones de dólares.
-
primeros indicios, tras investigaciones de los grupos de Matzke, Jorgensen y Limbdo, de la existencia de mecanismos de silenciamiento génico, que permitirían años más tarde desarrollar técnicas claves para la biotecnología
-
Calgene conduce el primer ensayo de campo exitoso con plantas de algodón transgénicas (tolerantes al herbicida Bromoxynil), y Michael Fromm, reporta la transformación estable del maíz usando una pistola génica de alta velocidad. Además, GenPharm International, Inc. desarrolla la primer vaca transgénica para producir proteínas humanas en su leche para la formulación de leches para bebés. Ese año, se lleva a cabo el primer protocolo de terapia génica, en una niña de 4 años con una enfermedad autoi
-
En Argentina se crea una instancia de consulta y apoyo técnico para asesorar al Secretario de Agricultura, Ganadería, Pesca y Alimentación en la formulación e implementación de la regulación para la introducción y liberación al ambiente de materiales animales y vegetales obtenidos mediante Ingeniería Genética: la Comisión Nacional Asesora de Biotecnología Agropecuaria (CONABIA).
-
Se reporta la transformación estable de trigo. Alrededor de 400 ensayos de campo con cultivos transgénicos se realizan en todo el mundo. Ya se obtienen plantas transgénicas con composición modificada de hidratos de carbono, y de ácidos grasos.
-
La FDA aprueba el primer cultivo genéticamente modificado utilizado como alimento: el tomate Flavr Savr. Para obtenerlo, se introduce el gen que codifica para la enzima poligalacturonasa en una disposición particular para que, al transcribirse, genere moléculas de ARN complementarias al ARNm de poligalacturonasa propio de la planta, impidiendo así su traducción. Dado que dicha enzima es la responsable de degradar la pectina (componente de la pared celular vegetal que le da firmeza a la misma)
-
Un grupo de investigadores logra transplantar corazones de cerdos genéticamente modificados a babuinos (primates), probando la posibilidad de los xenotransplantes (transplante de un órgano o de un tejido desde un animal a otro de distinta especie). En diciembre del mismo año, se realiza en el Hospital General de San Francisco, el primer transplante de médula ósea (pretratada) de un babuino a un paciente humano enfermo de Sida, con la intención de reforzar su sistema inmunológico con células
-
El gobierno del Reino Unido anuncia que 10 personas se han infectado con el agente BSE (causante del “Mal de la vaca loca” en animales) por exposición a carne contaminada. Se reporta la secuenciación del genoma completo de la levadura Saccharomyces cerevisiae, utilizada para la fabricación del vino, del pan y de la cerveza. Se secuencian también los genomas de un grupo de bacterias particulares que habitan ambientes extremos (temperaturas muy extremas, concentración de sal muy elevada, etc.
-
Investigadores del Instituto Roslin de Escocia, reportan el clonado de una oveja, conocida mundialmente como Dolly, a partir de una célula de la ubre de una oveja adulta. Se completa la secuenciación del genoma de Borrelia burgdorferi, patógeno causal de la enfermedad de Lyme, junto con los genomas de Escherichia coli y Helicobacter pylori (bacteria causal de la úlcera gástrica). También se aprueba el Rituxan, el primer medicamento para una terapia anticancerígena basada en anticuerpos
-
Científicos de la Universidad de Hawaii clonan tres generaciones de ratones a partir de un núcleo de células del cúmulo de un ratón adulto, y científicos de Japón clonan ocho terneros usando células de una vaca adulta. Además, dos equipos de científicos logran crecer células madre embrionarias, un anhelo perseguido por mucho tiempo. Por otro lado, la FDA aprueba el primer agente terapéutico basado en la estrategia de ácido nucleico antisentido: Fomivirsen. Es un agente antiviral para el tratamie
-
: Se completa la primera secuencia de un cromosoma humano, el cromosoma 22.
Want to make a timeline like this?
Use Timetoast to turn dates, events, milestones, and phases into a clear visual timeline you can build and share. Timetoast is a timeline maker for work, school, research, and stories.